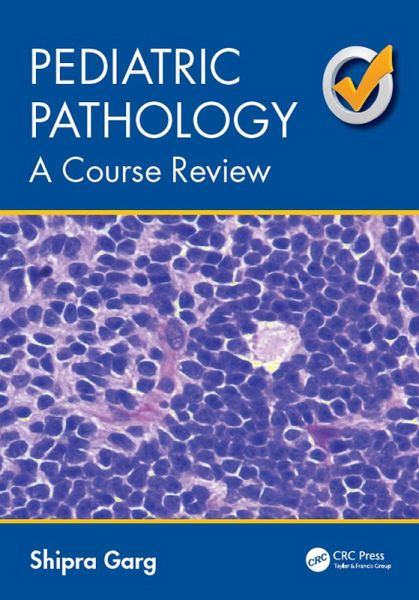

Pediatric Pathology (eBook, PDF)
A Course Review
Versandkostenfrei!
Sofort per Download lieferbar
103,95 €
inkl. MwSt.
Weitere Ausgaben:
PAYBACK Punkte
52 °P sammeln!
This book serves as a quick study guide during the stages of examination preparation for the pediatric pathology boards. The material covers most of the major topics in pediatric pathology including the fetal, perinatal, infant, child, and organ system pathology. It includes a short quiz containing 115 questions with photomicrographs for each, and an answer key inserted at the end of the book.
Dieser Download kann aus rechtlichen Gründen nur mit Rechnungsadresse in A, B, BG, CY, CZ, D, DK, EW, E, FIN, F, GR, HR, H, IRL, I, LT, L, LR, M, NL, PL, P, R, S, SLO, SK ausgeliefert werden.